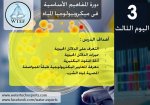
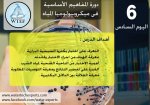

دورة المفاهيم الأساسية فى ميكروبيولوجيا المياه
وهى دورة مجانية عبر صفحات جروب خبراء معالجة المياه
وستكون فى الفترة من 16 حتى 27 اكتوبر 2016
هدف الدورة :
- الفهم الجيد فلسفة الاختبارات الميكروبيولوجية ودلالاتها .
- اجراء الاختبارات المطلوبة للمعايير الميكروبيولوجية .
- القدرة على تفسير النتائج وفهم العلاقات بينها.
الفئة المستهدفة للحضور :
- الدورة موجهة لغير المتخصصين العامليين فى مجال المياه وللمبتدأين فى معامل ميكروبيولوجي المياه ولا يشترط وجود خبرة سابقة .
المحتوى العلمى للدورة :
تشمل الدورة المواضيع الهامة التالية :
1. مقدمة عامة عن ميكروبيولوجيا المياه
2. اختبار العدّ الكلى للبكتريا Total Plate Count
3. الدلائل الحيوية ( كاشفات التلوث) Microbial Indicator
4. اختبار بكتيريا القولون الكلية Total Coliform
5. اختبار بكتريا القولون البرازية Fecal Coliform
6. اختبار بكتريا السبحية البرازية Fecal Streptoccus
7. الفحص البيولوجى للمياه Biological Examination
8. الفحص البيولوجى للكشف عن البرتوزوا Protozoa
9. الفحص البيولوجى للكشف عن الطحالب Algae
وسيكون عقب كل يوم اسئلة للنقاش حول محتوى كل درس للتأكد من وصول المعلومة وللاستفادة من خبرات الجميع .
وقد تم وضع هذه الدورة طبقاً للمواصفات القياسية لمياه الشرب بحيث تغطى هذه الدورة كل المعايير المكروبيولوجية خلال عشرة ايام بحيث يتم كل يوم شرح احد الدروس متبوعاً بأحد الاسئلة العملية للنقاش حولها والتأكد من فهم الدرس وفى اليوم العاشر والاخير باذن الله سيكون هناك اختبار على ما تم دارسته فى الايام السابقة بالدورة.
الدورة مجانية وستكون عبر جروب خبراء معالجة المياه على الرابط التالى :
Www.facebook.com/groups/waterexperts
يسعدنا مشاركاك بنشر الاعلان على المعارف والاصدقاء وعلى اوسع نطاق من إجل افادة الجميع .. ويشرفنا حضوركم معنا من اجل تبادل الخبرات العلمية بين اعضاء الجروب من مختلف الأقطار العربية .
المرفقات
-
44.6 KB المشاهدات: 1,550